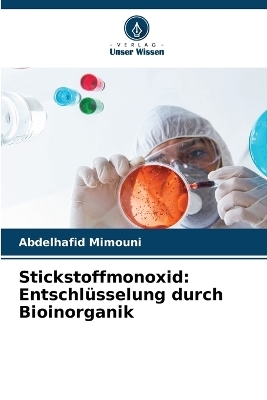
Stickstoffmonoxid - Abdelhafid Mimouni

Stickstoffmonoxid
Entschlüsselung durch Bioinorganik
Seiten
2024
Verlag Unser Wissen
978-620-7-61320-5 (ISBN)
Verlag Unser Wissen
978-620-7-61320-5 (ISBN)
- Keine Verlagsinformationen verfügbar
- Artikel merken
Stickstoffmonoxid Revealed by Bioinorganic" untersucht eingehend die lebenswichtige Rolle von Stickstoffmonoxid (NO) in verschiedenen biologischen Prozessen, wobei der Schwerpunkt auf seiner Interaktion mit Metallverbindungen liegt. Das Buch untersucht die Mechanismen der NO-Produktion, seine physiologischen Eigenschaften und seinen Einfluss auf Schlüsselsysteme wie das Herz-Kreislauf- und das Immunsystem. Unter Einbeziehung der Prinzipien der Bioanorganik beleuchtet es die Verbindungen zwischen Metallen und NO und vermittelt so ein tieferes Verständnis ihrer Bedeutung in der Biologie. Mit einer detaillierten Analyse und robusten wissenschaftlichen Referenzen ist dieses Buch eine wichtige Ressource für Forscher, Studenten und Berufstätige, die sich für die bioinorganische Chemie und ihre biologischen Auswirkungen interessieren.
Dr. Abdelhafid Mimouni ist ein unabhängiger Forscher, der sich auf die Chemie bioinorganischer Systeme spezialisiert hat und über umfassende Kenntnisse in der makromolekularen Synthese und Charakterisierung verfügt. Er promovierte 1997 an der Universität Paris XII in Chemie und 1993 an der Universität ParisXI in bioinorganischen Systemen.
| Erscheinungsdatum | 05.06.2024 |
|---|---|
| Sprache | deutsch |
| Maße | 152 x 229 mm |
| Gewicht | 97 g |
| Themenwelt | Naturwissenschaften ► Chemie ► Technische Chemie |
| Technik | |
| Schlagworte | NMR |
| ISBN-10 | 620-7-61320-1 / 6207613201 |
| ISBN-13 | 978-620-7-61320-5 / 9786207613205 |
| Zustand | Neuware |
| Informationen gemäß Produktsicherheitsverordnung (GPSR) | |
| Haben Sie eine Frage zum Produkt? |
Mehr entdecken
aus dem Bereich
aus dem Bereich
Daten, Formeln, Normen, vergleichende Betrachtungen
Buch | Softcover (2024)
Europa-Lehrmittel (Verlag)
CHF 56,90


